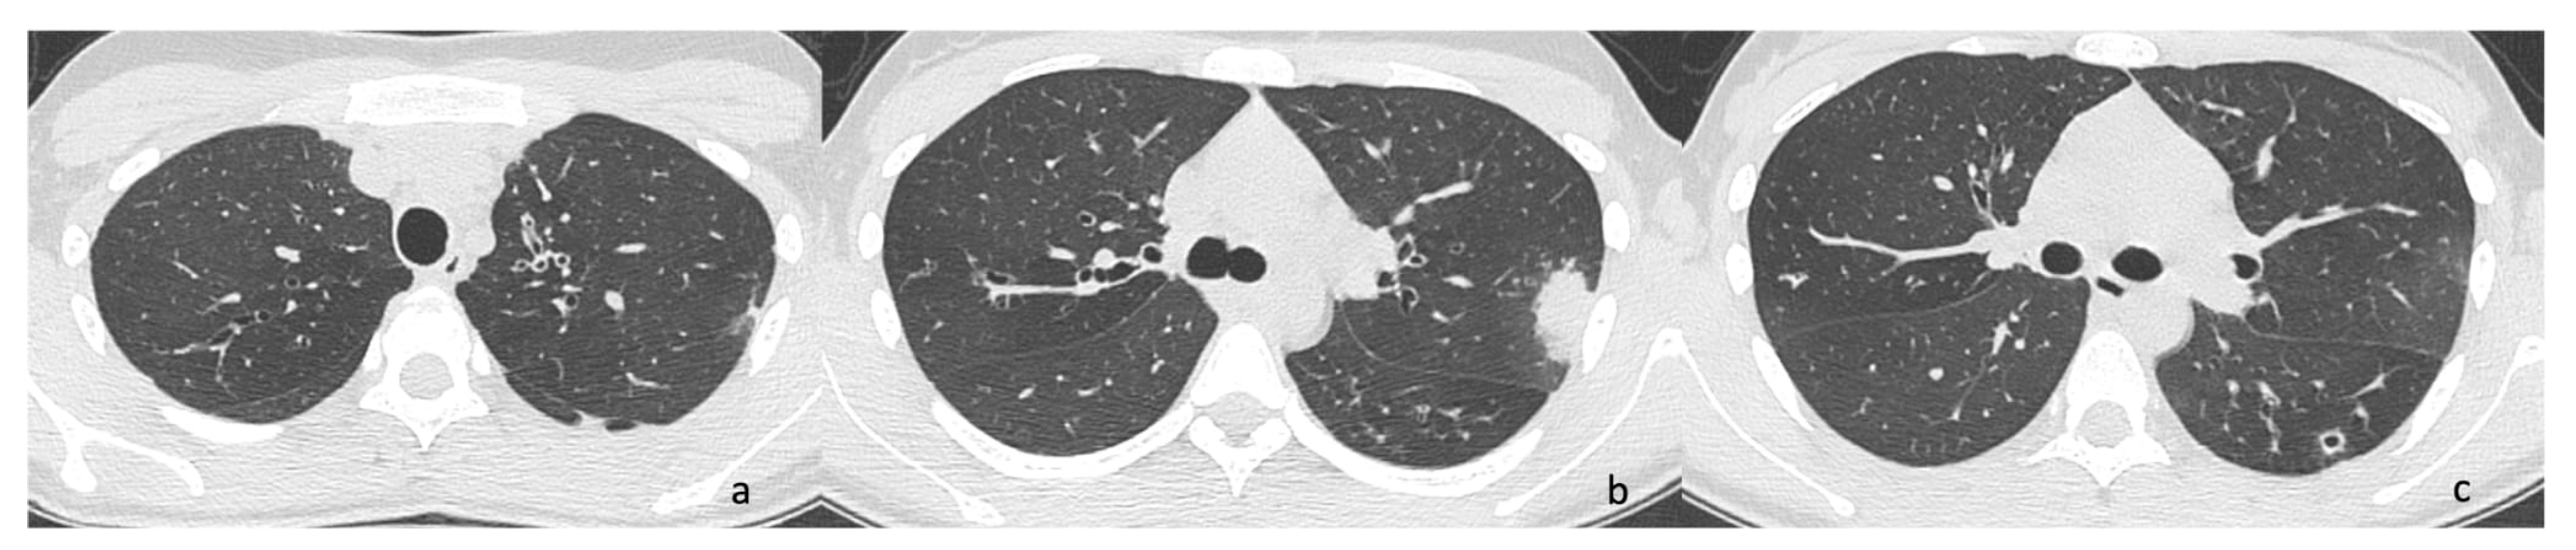
Antibiotics 14 00317 g002

Nocardia Isolation in People with Cystic Fibrosis and Non-CF Bronchiectasis: A Multicenter Italian Study
Abstract
1. Introduction
2. Results
2.1. Case 1
2.2. Case 2
2.3. Case 3
2.4. Case 4
3. Discussion
4. Materials and Methods
Author Contributions
Funding
Institutional Review Board Statement
Informed Consent Statement
Data Availability Statement
Acknowledgments
Conflicts of Interest
Abbreviations
| CF | Cystic fibrosis |
| CT | Computed tomography |
| ETI | Elexacaftor/Ttezacaftor/Iivacaftor |
| FEV1 | Forced expiratory volume in the first second |
| MRI | Magnetic Resonance Imaging |
| MSSA | Meticilline sensitive Staphylococcus aureus |
| NGS | Next-generation sequencing |
| PA | Pseudomonas aeruginosa |
| PCD | Primary Ciliary Dyskinesia |
| pwCF | People with cystic fibrosis |
| SAC | S. apiospermum complex |
| ST | Sweat test |
| TMP-SMX | Trimethoprim-sulfamethoxazole |
References
- Woodworth, M.H.; Saullo, J.L.; Lantos, P.M.; Cox, G.M.; Stout, J.E. Increasing Nocardia Incidence Associated with Bronchiectasis at a Tertiary Care Center. Ann. Am. Thorac. Soc. 2017, 14, 347–354. [Google Scholar] [CrossRef] [PubMed]
- Martínez Tomás, R.; Menéndez Villanueva, R.; Reyes Calzada, S.; Santos Durantez, M.; Vallés Tarazona, J.M.; Modesto Alapont, M.; Gobernado Serrano, M. Pulmonary Nocardiosis: Risk Factors and Outcomes. Respirology 2007, 12, 394–400. [Google Scholar] [CrossRef] [PubMed]
- Perea, L.; Faner, R.; Chalmers, J.D.; Sibila, O. Pathophysiology and Genomics of Bronchiectasis. Eur. Respir. Rev. 2024, 33, 240055. [Google Scholar] [CrossRef]
- Cole, P.J. Inflammation: A Two-Edged Sword--the Model of Bronchiectasis. Eur. J. Respir. Dis. Suppl. 1986, 147, 6–15. [Google Scholar]
- Chalmers, J.D.; Polverino, E.; Crichton, M.L.; Ringshausen, F.C.; De Soyza, A.; Vendrell, M.; Burgel, P.R.; Haworth, C.S.; Loebinger, M.R.; Dimakou, K.; et al. Bronchiectasis in Europe: Data on Disease Characteristics from the European Bronchiectasis Registry (EMBARC). Lancet Respir. Med. 2023, 11, 637–649. [Google Scholar] [CrossRef]
- Hasegawa, A.; Tone, K.; Baba, Y.; Saito, Z.; Akutsu, T.; Kitayama, T.; Inaki, S.; Gochi, M.; Yaguchi, T.; Makimura, K.; et al. Nodular-Bronchiectatic Pattern in Pulmonary Nocardiosis: Immune Status and Treatment Outcomes in a Multicenter Retrospective Study. Respir. Med. 2025, 237, 107922. [Google Scholar] [CrossRef]
- Terlizzi, V.; Ballerini, T.; Castaldo, A.; Dolce, D.; Campana, S.; Taccetti, G.; Chiappini, E. Clinical Features and Outcomes of Persons with Cystic Fibrosis and Nocardia Isolation: A Systematic Review. BMC Pulm. Med. 2024, 24, 440. [Google Scholar] [CrossRef]
- Duan, J.; Li, C.; Jiang, Y.; Liu, C.; Huang, P.; Gao, L.; Guan, W.; Cheng, L.-L. Microbiological Characteristics of the Lower Airway in Adults with Bronchiectasis: A Prospective Cohort Study. Respir. Res. 2024, 25, 283. [Google Scholar] [CrossRef]
- Terlizzi, V.; Farrell, P.M. Update on Advances in Cystic Fibrosis towards a Cure and Implications for Primary Care Clinicians. Curr. Probl. Pediatr. Adolesc. Health Care 2024, 54, 101637. [Google Scholar] [CrossRef]
- Southern, K.W.; Burgel, P.-R.; Castellani, C.; De Boeck, K.; Davies, J.C.; Dunlevy, F.; Fajac, I.; Gramegna, A.; Lammertyn, E.; Middleton, P.G.; et al. Standards for the Care of People with Cystic Fibrosis (CF). J. Cyst. Fibros. 2023, 22, 961–962. [Google Scholar] [CrossRef]
- Lee, T.W.R.; Brownlee, K.G.; Conway, S.P.; Denton, M.; Littlewood, J.M. Evaluation of a New Definition for Chronic Pseudomonas Aeruginosa Infection in Cystic Fibrosis Patients. J. Cyst. Fibros. 2003, 2, 29–34. [Google Scholar] [CrossRef] [PubMed]
- Barrio, M.I.; Martínez, M.C.; Prados, C.; Girón, R.M.; Maiz, L.; Martínez, M.T. Isolation of Nocardia Species in Patients With Cystic Fibrosis. Arch. Bronconeumol. (Engl. Ed.) 2008, 44, 109–112. [Google Scholar] [CrossRef]
- Urbantat, R.M.; Pioch, C.; Ziegahn, N.; Stegemann, M.; Stahl, M.; Mall, M.A.; Röhmel, J.F. Pleuropneumonia Caused by Nocardia Cyriacigeorgica in a 14-Year-Old Girl with PCD. Eur. Respir. J. 2022, 60, 2427. [Google Scholar]
- Cordioli, G.; Di Pietra, G.; Asa’ad, S.; Meneghello, S.; Del Vecchio, C.; De Canale, E.; Castagliuolo, I. Nocardia Infections in Italy: From a Local to a National View. New Microbiol. 2023, 46, 68–74. [Google Scholar]
- Taccetti, G.; Terlizzi, V.; Campana, S.; Dolce, D.; Ravenni, N.; Fevola, C.; Francalanci, M.; Galici, V.; Neri, A.S. Antibiotic Treatment of Bacterial Lung Infections in Cystic Fibrosis. Eur. J. Pediatr. 2024, 184, 82. [Google Scholar] [CrossRef]
- Heirali, A.; McKeon, S.; Purighalla, S.; Storey, D.G.; Rossi, L.; Costilhes, G.; Drews, S.J.; Rabin, H.R.; Surette, M.G.; Parkins, M.D. Assessment of the Microbial Constituents of the Home Environment of Individuals with Cystic Fibrosis (CF) and Their Association with Lower Airways Infections. PLoS ONE 2016, 11, e0148534. [Google Scholar] [CrossRef]
- Ye, J.; Li, Y.; Hao, J.; Song, M.; Guo, Y.; Gao, W.; Zheng, C.; Huang, Y.; Feng, Z.; Zhang, L. Rare Occurrence of Pulmonary Coinfection Involving Aspergillus Fumigatus and Nocardia Cyriacigeorgica in Immunocompetent Patients Based on NGS: A Case Report and Literature Review. Medicine 2023, 102, e36692. [Google Scholar] [CrossRef]
- Yang, C.L.; Gaffin, J.M.; Radhakrishnan, D. Question 3: Can We Diagnose Asthma in Children under the Age of 5 Years? Paediatr. Respir. Rev. 2019, 29, 25–30. [Google Scholar] [CrossRef]
- Garcia Rueda, J.E.; Monsalve Naranjo, A.D.; Giraldo Benítez, C.; Ramírez Quintero, J.D. Suppurative Thyroiditis: Coinfection by Nocardia Spp. and Mycobacterium Tuberculosis in an Immunocompromised Patient. Cureus 2024, 16, e65744. [Google Scholar] [CrossRef]
- Tokita, N.; Urabe, N.; Sakamoto, S.; Yamaguchi, A.; Sekiguchi, R.; Kishi, K. Co-infection with Nocardia spp. in a Patient Wit h Mycobacterium Avium Complex Pulmonary Disease: A Case Report. Respirol. Case Rep. 2022, 10, e01036. [Google Scholar] [CrossRef]
- Huang, H.-Y.; Bu, K.-P.; Liu, J.-W.; Wei, J. Overlapping Infections of Mycobacterium canariasense and Nocardia farcinica in an Immunocompetent Patient: A Case Report. World J. Clin. Cases 2024, 12, 2079–2085. [Google Scholar] [CrossRef] [PubMed]
- Milczewska, J.; Syunyaeva, Z.; Żabińska-Jaroń, A.; Sands, D.; Thee, S. Changing Profile of Bacterial Infection and Microbiome in Cystic Fibrosis: When to Use Antibiotics in the Era of CFTR-Modulator Therapy. Eur. Respir. Rev. 2024, 33, 240068. [Google Scholar] [CrossRef] [PubMed]
- Beck, M.R.; Hornick, D.B.; Pena, T.A.; Singh, S.B.; Wright, B.A. Impact of Elexacaftor/Tezacaftor/Ivacaftor on Bacterial Cultures from People with Cystic Fibrosis. Pediatr. Pulmonol. 2023, 58, 1569–1573. [Google Scholar] [CrossRef]
- Nichols, D.P.; Morgan, S.J.; Skalland, M.; Vo, A.T.; Van Dalfsen, J.M.; Singh, S.B.P.; Ni, W.; Hoffman, L.R.; McGeer, K.; Heltshe, S.L.; et al. Pharmacologic Improvement of CFTR Function Rapidly Decreases Sputum Pathogen Density, but Lung Infections Generally Persist. J. Clin. Investig. 2023, 133, e167957. [Google Scholar] [CrossRef]
- Dittrich, A.-M.; Sieber, S.; Naehrlich, L.; Burkhart, M.; Hafkemeyer, S.; Tümmler, B.; Registry Working Group of the German CF Registry. Use of Elexacaftor/Tezacaftor/Ivacaftor Leads to Changes in Detection Frequencies of Staphylococcus Aureus and Pseudomonas Aeruginosa Dependent on Age and Lung Function in People with Cystic Fibrosis. Int. J. Infect. Dis. 2024, 139, 124–131. [Google Scholar] [CrossRef]
- Gavey, R.; Nolan, J.; Moore, V.; Reid, D.; Brown, J. Clinical and Radiological Improvement of Cavitary Mycobacteroides Abscessus Disease in Cystic Fibrosis Following Initiation of Elexacaftor/Tezacaftor/Ivacaftor. J. Cyst. Fibros. 2024, 23, 1024–1026. [Google Scholar] [CrossRef]
- Wiesel, V.; Aviram, M.; Mei-Zahav, M.; Dotan, M.; Prais, D.; Cohen-Cymberknoh, M.; Gur, M.; Bar-Yoseph, R.; Livnat, G.; Goldbart, A.; et al. Eradication of Nontuberculous Mycobacteria in People with Cystic Fibrosis Treated with Elexacaftor/Tezacaftor/Ivacaftor: A Multicenter Cohort Study. J. Cyst. Fibros. 2024, 23, 41–49. [Google Scholar] [CrossRef]
- McParland, C.; Nunn, M.; Marras, T.K.; Chiasson, M. Eradication of Mycobacterium Abscessus Infection in Cystic Fibrosis with Initiation of Elexacaftor/Tezacaftor/Ivacaftor. J. Cyst. Fibros. 2024, 23, 38–40. [Google Scholar] [CrossRef]
- Armbruster, C.R.; Hilliam, Y.K.; Zemke, A.C.; Atteih, S.; Marshall, C.W.; Moore, J.; Koirala, J.; Krainz, L.; Gaston, J.R.; Lee, S.E.; et al. Persistence and Evolution of Pseudomonas Aeruginosa Following Initiation of Highly Effective Modulator Therapy in Cystic Fibrosis. mBio 2024, 15, e0051924. [Google Scholar] [CrossRef]
- Menendez, R.; Cordero, P.; Santos, M.; Gobernado, M.; Marco, V. Pulmonary Infection with Nocardia Species: A Report of 10 Cases and Review. Eur. Respir. J. 1997, 10, 1542–1546. [Google Scholar] [CrossRef]
- Su, R.; Wen, Y.; Liufu, Y.; Pan, X.; Guan, Y. The Computed Tomography Findings and Follow-up Course of Pulmonary Nocardiosis. J. Comput. Assist. Tomogr. 2023, 47, 418–423. [Google Scholar] [CrossRef] [PubMed]
- Kanne, J.P.; Yandow, D.R.; Mohammed, T.-L.H.; Meyer, C.A. CT Findings of Pulmonary Nocardiosis. Am. J. Roentgenol. 2011, 197, W266–W272. [Google Scholar] [CrossRef]
- Thorn, S.T.; Brown, M.A.; Yanes, J.J.; Sherrill, D.L.; Pugmire, J.; Anderson, K.A.; Klotz, S.A. Pulmonary Nocardiosis in Cystic Fibrosis. J. Cyst. Fibros. 2009, 8, 316–320. [Google Scholar] [CrossRef]
- Mei-Zahav, M.; Livnat, G.; Bentur, L.; Mussaffi, H.; Prais, D.; Stafler, P.; Bar-On, O.; Steuer, G.; Blau, H. The Spectrum of Nocardia Lung Disease in Cystic Fibrosis. Pediatr. Infect. Dis. J. 2015, 34, 909–911. [Google Scholar] [CrossRef]
- Dagan, A.; Keller, N.; Vilozni, D.; Ramon-Saraf, R.; Bar, B.-E.; Sarouk, I.; Ashkenazi, M.; Lavie, M.; Efrati, O. Nocardia Colonization: A Risk Factor for Lung Deterioration in Cystic Fibrosis Patients? Med. Sci. Monit. 2015, 21, 1889–1894. [Google Scholar] [CrossRef]
- Terlizzi, V.; Tomaselli, M.; Giacomini, G.; Dalpiaz, I.; Chiappini, E. Stenotrophomonas Maltophilia in People with Cystic Fibrosis: A Systematic Review of Prevalence, Risk Factors and Management. Eur. J. Clin. Microbiol. Infect. Dis. 2023, 42, 1285–1296. [Google Scholar] [CrossRef]
- Restrepo, A.; Clark, N.M.; on behalf of the Infectious Diseases Community of Practice of the American Society of Transplantation. Nocardia Infections in Solid Organ Transplantation: Guidelines from the Infectious Diseases Community of Practice of the American Society of Transplantation. Clin. Transplant. 2019, 33, e13509. [Google Scholar] [CrossRef]
- Lederman, E.R.; Crum, N.F. A Case Series and Focused Review of Nocardiosis: Clinical and Microbiologic Aspects. Medicine 2004, 83, 300–313. [Google Scholar] [CrossRef]
- Yetmar, Z.A.; Khodadadi, R.B.; Chesdachai, S.; McHugh, J.W.; Challener, D.W.; Wengenack, N.L.; Bosch, W.; Seville, M.T.; Beam, E. Epidemiology, Timing, and Secondary Prophylaxis of Recurrent Nocardiosis. Open Forum Infect. Dis. 2024, 11, ofae122. [Google Scholar] [CrossRef]
- Yetmar, Z.A.; Khodadadi, R.B.; Chesdachai, S.; McHugh, J.W.; Clement, J.; Challener, D.W.; Wengenack, N.L.; Bosch, W.; Seville, M.T.; Beam, E. Trimethoprim-Sulfamethoxazole Dosing and Outcomes of Pulmonary Nocardiosis. Infection 2025, 53, 83–94. [Google Scholar] [CrossRef]
- Chirila, R.M.; Harris, D.; Gupta, V.; Hata, D.J.; Matei, C.; Alvarez, S.; Dumitrascu, A.G. Clinical and Radiological Characterization of Central Nervous System Involvement in Nocardiosis: A 20-Year Experience. Cureus 2024, 16, e52950. [Google Scholar] [CrossRef] [PubMed]
- Liu, Y.; Wu, S.-Y.; Deng, J.; Zhuang, K.-W.; Tang, Y.; Wu, N.; Zhang, W.-L.; Liao, Q.-F.; Xiao, Y.-L.; Kang, M. Application of MALDI-TOF Mass Spectrometry for Identification of Nocardia Species. BMC Microbiol. 2024, 24, 358. [Google Scholar] [CrossRef]

| Patient ID | Age | Coinfection | Clinical Symptoms | Imaging | FEV1 (%) | BMI (Kg/m2) | Treatment and Duration | Eradication | ||
|---|---|---|---|---|---|---|---|---|---|---|
| PRE | POST | PRE | POST | |||||||
| FI01 | 33 | PA; A. fumigatus; SAC | None | Rx: not acute changes in known bronchiectasis | 61 | 61 | 20.5 | 20.4 | TMP-SMX (30 days) | No |
| 36 | PA; SAC | None | NA | 59 | 65 | 21.4 | 20.8 | None | No | |
| 37 | PA; SAC | More viscous secretions | NA | 65 | 66 | 20.8 | 20.9 | Ciprofloxacin (14 days) | No | |
| 38 | PA; SAC | Fever and cough | Rx: right basal consolidation, with pleural effusion | 59 | 62 | 20.8 | 20.5 | Ceftazidime and Tobramycin (14 days) | No | |
| 39 | PA; A. fumigatus; SAC | Fever and cough | Rx: bronchiectasis | 63 | 55 | 21.6 | 21.4 | TMP-SMX and Ciprofloxacin (14 days) | No | |
| 40 | PA | Cough | NA | 65 | 61 | 21.0 | 21.0 | None | Yes | |
| CE01 | 26 | PA; MSSA | Fever, cough; hemoptysis, lymphadenitis | Rx: left apical consolidation in known bronchiectasis | 84 | 98 | 19.2 | 19.5 | Amoxicillin-Clavulanic acid and TMP-SMX (14 days) | Yes |
| Patient ID | Age | Coinfection | Clinical Symptoms | Imaging | FEV1 (%) | BMI (Kg/m2) | Treatment and Duration | Eradication | ||
|---|---|---|---|---|---|---|---|---|---|---|
| PRE | POST | PRE | POST | |||||||
| CE02 | 26 | Klebsiella pneumoniae; Serratia marcescens | Fever, cough | Chest CT: consolidation in known bronchiectasis | 73 | 87 | 23.4 | 25.1 | Amikacin and Cefotaxime (14 days) | Yes |
| 26 | Klebsiella pneumoniae; PA | Cough, more viscous secretions | Chest X-rays: not acute changes. | 83 | 92 | 24.0 | 23.0 | Amikacin and Linezolid (14 days) | ||
| VE01 | 18 | Haemophilus spp.; PA | Cough, increased secretions | Chest CT: consolidation and mucous plugs, new tree in bud aspect in the lingula, upper and lower lobe, left lower lobe consolidation. | 94 | 107 | 19.59 | NA | Amikacin and Ceftazidime (14 days) ˜ | No |
| Cough, increased secretions | Chest X-rays: medium lobe consolidation | 99 | 110 | 19.92 | NA | TMP-SMZ (14 days) | Yes | |||
Disclaimer/Publisher’s Note: The statements, opinions and data contained in all publications are solely those of the individual author(s) and contributor(s) and not of MDPI and/or the editor(s). MDPI and/or the editor(s) disclaim responsibility for any injury to people or property resulting from any ideas, methods, instructions or products referred to in the content. |
© 2025 by the authors. Licensee MDPI, Basel, Switzerland. This article is an open access article distributed under the terms and conditions of the Creative Commons Attribution (CC BY) license (https://creativecommons.org/licenses/by/4.0/).
Share and Cite
Venditto, L.; Dolce, D.; Campana, S.; Vitullo, P.; Di Maurizio, M.; Fevola, C.; Lucca, F.; Taccetti, G.; Terlizzi, V. Nocardia Isolation in People with Cystic Fibrosis and Non-CF Bronchiectasis: A Multicenter Italian Study. Antibiotics 2025, 14, 317. https://doi.org/10.3390/antibiotics14030317
Venditto L, Dolce D, Campana S, Vitullo P, Di Maurizio M, Fevola C, Lucca F, Taccetti G, Terlizzi V. Nocardia Isolation in People with Cystic Fibrosis and Non-CF Bronchiectasis: A Multicenter Italian Study. Antibiotics. 2025; 14(3):317. https://doi.org/10.3390/antibiotics14030317
Chicago/Turabian StyleVenditto, Laura, Daniela Dolce, Silvia Campana, Pamela Vitullo, Marco Di Maurizio, Cristina Fevola, Francesca Lucca, Giovanni Taccetti, and Vito Terlizzi. 2025. "Nocardia Isolation in People with Cystic Fibrosis and Non-CF Bronchiectasis: A Multicenter Italian Study" Antibiotics 14, no. 3: 317. https://doi.org/10.3390/antibiotics14030317
APA StyleVenditto, L., Dolce, D., Campana, S., Vitullo, P., Di Maurizio, M., Fevola, C., Lucca, F., Taccetti, G., & Terlizzi, V. (2025). Nocardia Isolation in People with Cystic Fibrosis and Non-CF Bronchiectasis: A Multicenter Italian Study. Antibiotics, 14(3), 317. https://doi.org/10.3390/antibiotics14030317







